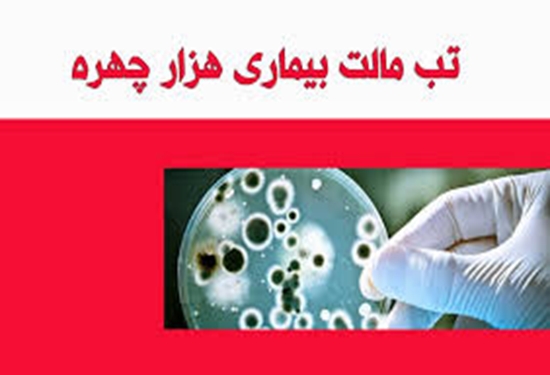

ابتلای واکسیناتور شبکه دامپزشکی شهرستان سملقان در حین واکسیناسیون به بیماری تب مالت
یکی از همکاران واکسیناتور شبکه دامپزشکی شهرستان سملقان در حین واکسیناسیون دام سبک به بیماری تب مالت مبتلا شد.
به گزارش روابط عمومی شبکه دامپزشکی سملقان، محمدرضا سروناز رییس شبکه دامپزشکی شهرستان خبر داد: با وجود رعایت کامل مسائل ایمنی فردی توسط کارکنان این شبکه، یکی از کارکنان در حین انجام واکسیناسیون دامهای سبک، به صورت کاملا سهوی سرنگ حاوی واکسن زنده تخفیف حدت یافته بروسلوز (تب مالت) به دست وی تزریق شده و وی به بیماری تب مالت مبتلا شده است که به طور معمول این امری اجتناب ناپذیر در حرفه دامپزشکی میباشد.
سروناز رییس شبکه دامپزشکی شهرستان ادامه داد: با وجود تمامی مشقت های شغلی در این حوزه، کارشناسان و تکنسین های دامپزشکی با کمترین ادعا در سخت ترین شرایط کاری به منظور حفظ و حراست از سرمایه های دامی شهرستان و افزایش سطح بهداشت عمومی در جامعه مشغول به خدمت خالصانه هستند و این یکی از خطرات و سختی های کار در حوزه دامپزشکی می باشد که پرسنل زحمت کش آن با هدف مبارزه با بیماری های مشترک قابل انتقال بین انسان و دام به جان می خرند.
سروناز تصریح کرد: به دلیل شرایط خاص کار در حرفه دامپزشکی همچون کار در آزمایشگاه، دامداری، کشتارگاه، روستا و مناطق عشایری این مخاطرات اجتناب ناپذیر است و همواره تعدادی از همکاران ما دچار حوادثی از جمله ابتلا به بیماری های مشترک بین انسان و دام (همچون تب مالت) ، حیوان گزیدگی و ... می شوند.
وی افزود: به همین دلیل است که حرفه دامپزشکی در ردیف ۱۰ شغل خطرناک دنیا قرار گرفته و در بسیاری از کشورها جزو مشاغل سخت و زیان آور به حساب میآید.



نظر دهید